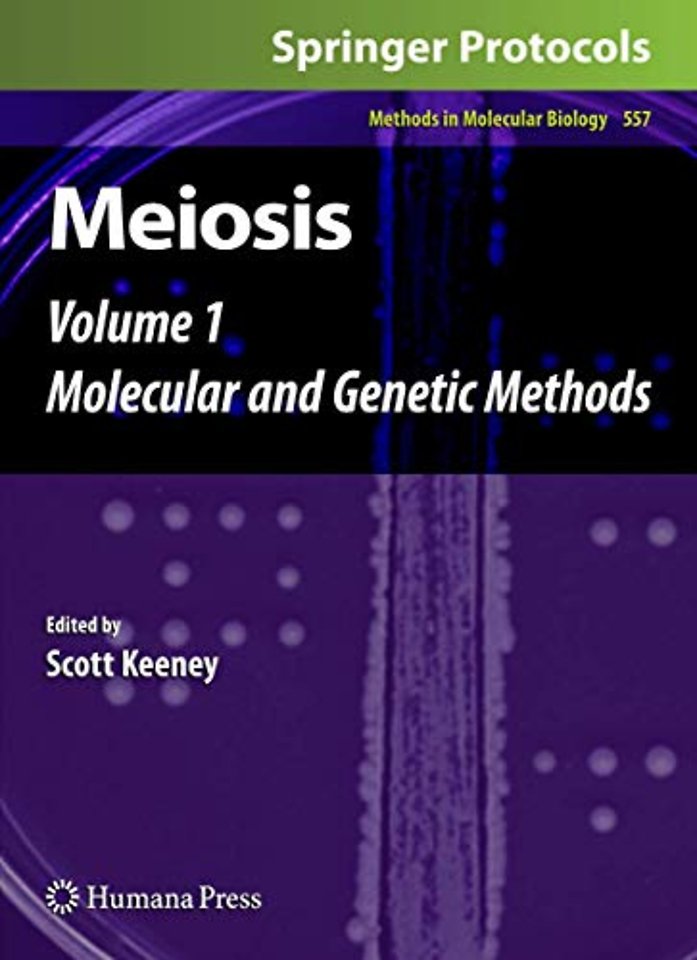

Meiosis
Volume 1, Molecular and Genetic Methods
Samenvatting
Each generation in a sexually reproducing organism such as a fly or a mouse passes through the bottleneck of meiosis, which is the specialized cell division that gives rise to haploid reproductive cells (sperm, eggs, spores, etc. ). The principal function of meiosis is to reduce the genome complement by half, which is accomplished through sequential execution of one round of DNA replication followed by two rounds of chromosome segregation. Within the extended prophase between DNA replication and the first meiotic division in most organisms, homologous maternal and paternal chromosomes pair with one another and undergo homologous recombination, which establishes physical connections that link the homologous chromosomes until the time they are separated at anaphase I. Recombination also serves to increase genetic diversity from one generation to the next by breaking up linkage groups. The unique chromosome dynamics of meiosis have fascinated scientists for well over a century, but in recent years there has been an explosion of new information about how meiotic chromosomes pair, recombine, and are segregated. Progress has been driven by advances in three main areas: (1) genetic identification of meiosis-defective mutants and cloning of the genes involved; (2) development of direct physical assays for DNA intermediates and products of recombination; and (3) increasingly sophisticated cy- logical methods that describe chromosome behaviors and the spatial and temporal patterns by which specific proteins associate with meiotic chromosomes.